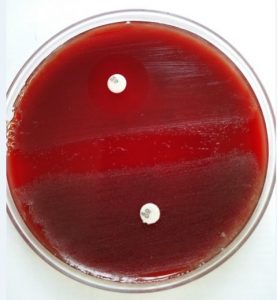
Optochin and Bacitracin Sensitivity of the isolates in Blood Agar - Optochin and bacitracin sensitivity of the isolates in Blood agar
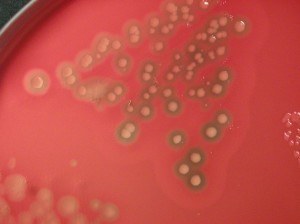
Double Zone hemolysis produced by Clostridium perfringens  - Double zone hemolysis produced byClostridium perfringens

Blood agar is an enriched bacterial growth medium. Fastidiousorganisms, such as streptococci, do not grow well on ordinary growth media but grow on blood agar. Blood agar is a growth medium with trypticase soyagar base enriched with 5% sheep blood.

Blood agar consists of a base containing a protein source (e.g. tryptones), soybean protein digest, sodium chloride (NaCl), agar, and 5% sheep blood.
Blood contains inhibitors for certain bacteria such as Neisseria and Haemophilus genera, so the blood agar must be heated to inactivate these inhibitors and to release essential growth factors (e.g., V factor). Heating of blood agar converts it into chocolate agar (heated blood turns a chocolate color) and supports the growth of these bacteria.
Composition of Blood Agar
Protein sources may differ among manufacturers and may be pancreatic digest of casein, papic digest of soy meal, neutralized peptone, yeast extract, or a combination of them. Please check the paper insert in the purchased media.
| Ingredients | Gram/liter |
|---|---|
| Beed heart peptone | 10 gm |
| Tryptose | 10 gm |
| Sodium chloride | 5 gm |
| Agar | 15 gm |
| Sheep blood | 5% |
| Final pH at 25 ° C 7.3 ± 0.2 |
Choice of the Blood
Sheep blood is the first choice to prepare BA plates, followed by horse, rabbit, or goat blood.
Human blood, particularly expired citrated donor blood, should not be used because this may contain substances inhibitory to the growth of some pathogens. Residual antibiotics in host blood and antibodies like ASO or anti-M protein could interfere with the growth of S. pyogenes. Citrate inhibits the growth of beta-hemolytic streptococci. Infected human blood may also contain infectious agents.
Preparation of Blood Agar
Preparation of blood agar from dehydrated blood agar base
- Prepare theBAbase as instructed by the manufacturer.
- Sterilize by autoclaving at 121°C for 15 minutes.
- Transfer thus preparedBA base to a 50°C water bath.
- When the agar base is cooled to 50°C, add sterile sheep blood aseptically and mix well gently. Avoid the formation of air bubbles. You must have warmed the blood to room temperature at the time of dispensing to the molten agar base.
- Dispense 15 ml amounts to sterile Petri plates aseptically
- Label the medium with the date of preparation and give it a batch number (if necessary).
- Store the plates at 2-8°C, preferably in sealed plastic bags to prevent loss of moisture. The shelf life of thus prepared BA is up to four weeks.
Note:If you are planning to prepare a batch of blood agar plates, prepare few blood agar plates first to ensure that blood is sterile.
Quality control of Blood Agar
- The pH of the blood agar range from 7.2 to 7.6 at room temperature.
- Inoculate the plates with 5-hour broth cultures of Streptococcus pyogenes and *S. pneumoniae.*Inoculate also a plate with H. influenzae and streak with S. aureus (i.e.Satellitism Test).
- Incubate the plates in a carbon dioxide-enriched atmosphere at 35-37°C overnight.
- Check for the growth characteristics of each species
S. pyogenes: Beta-hemolysis S. pneumoniae: Alpha-hemolysis Satellitism of H. influenzae
Uses of Blood Agar
Blood agar has two major uses:
- Isolation, identification (with the use of either optochin disc or bacitracin disc and testing the sensitivity of the isolate), and antimicrobial susceptibility of Streptococci.
- Determine the type of hemolysis, if any.****
Hemolysis

Certain bacterial species produce extracellular enzymes that lyse red blood cells in the blood agar (hemolysis). These hemolysins (exotoxin) radially diffuse outwards from the colonies causing complete or partial destruction of the red cells (RBC) in the medium and complete denaturation of hemoglobin within the cells to colorless products.
Four types of hemolysis are produced in sheep blood agar namely; alpha (α)hemolysis, beta (β)hemolysis, gamma (γ)hemolysis, and alpha prime or wide zone alpha hemolysis.
Hemolysis is best observed by examining colonies grown under anaerobic conditions or inspecting sub-surface colonies. Hold the BA plate must be up to a light source and observed with the light coming from behind (transmitted light)to know the type of hemolysis.
If either type of hemolysisis present, then one will observe a zone of hemolysissurrounding a growing colony.

Alpha (α)hemolysis
Alpha hemolysis is the partial lysis of RBCs to produce a greenish-grey or brownish discoloration around the bacterial colony. Alpha hemolysis is due to the reduction of RBC hemoglobin to methemoglobin in the medium surrounding the colony. Many of the alpha-hemolytic streptococci are part of the normal flora of humans but Streptococcus pneumonia****e which is also alpha-hemolytic causes serious pneumonia and other deadly infectious diseases.
Viridans group of streptococci also gives alpha-hemolysis.
Beta (β)Hemolysis
Beta-hemolysis is the complete lysis of RBCs, resulting in a distinct, clear,colorless zone surrounding and under the colony. The RBC membrane is destroyed. Organisms of Group A beta-hemolytic streptococci-Streptococcus pyogenesand Group B, beta-hemolytic streptococci**-Streptococcus agalactiace** are beta-hemolytic. The maximal activity of both the hemolysins (oxygen labile (SLO) and oxygen stable (SLS) hemolysins) of group A streptococci, is observed only in anaerobic conditions so beta-hemolytic colonies are better observed when plates are incubated in increased CO2 concentration.
Other beta-hemolytic organisms are Staphylococcus aureus, Listeria monocytogenes, and Bacillus cereus.
Gamma (γ)or non-hemolysis
Gamma-hemolysis indicates no hemolysis of RBCs.There is no change in the medium under and surrounding the colonies.
Alpha prime or wide zone alpha hemolysis
A small zone of intact erythrocytes immediately adjacent to bacterial colony, with a zone of complete red-cell hemolysis surrounding the zone of intact erythrocytes. This type of hemolysis may be confused with β-hemolysis.
Target Hemolysis
Clostridium perfringensare readily identified in the laboratory by its characteristic “double zone” hemolysis also known as target hemolysis.
Modifications in Blood Agar
Adding dyes and antibiotics helps make the blood agar selective to specific pathogens. The most common modification is the addition of the dye crystal violet, antibiotics kanamycin and neomycin, and heating of the blood agar to form chocolate agar.
Crystal Violet Blood Agar (CVBA)
CVBA can isolate and identify Group A, Beta-hemolytic streptococci.
Streptococcus pyogenes causes numerous infections in humans, including strep throat (Streptococcal pharyngitis), rheumatic fever, post-streptococcal glomerulonephritis, wound/skin infections (cellulitis, erysipelas, necrotizing fascitis, myonecrosis) is a beta-hemolytic Group A Streptococcus.
Adding crystal violet to the blood agar prevents the growth of Staphylococcus aureus and other oral commensals. For the preparations of CVBA, add 1 ml of 0.02% w/v crystal violet to every 1000 ml of Blood agar.
Neomycin Blood Agar
This modification is done by adding the neomycin stock solution to the blood agar. This agar acts as selective media for isolating group A streptococci (S pyogenes) and group B streptococci (S agalactiae).
Neomycin suppresses the growth of oral commensals and Gram-negative rods, facilitating the growth of obligate anaerobes. In 250 ml of blood agar, add 1 ml of working neomycin sulfate to prepare 70 mg/ml of neomycin blood agar.
The inoculated agar plate should be incubated under anaerobic conditions for 24-48 hours at 36 ±1℃. Group A streptococci (*S pyogenes)*colonies appear white to gray, small (1-2 mm), translucent or opaque with a zone of beta-hemolysis. In contrast, the growth of S agalactiaeor Group B streptococci in neomycin blood agar is moderate to high with a clear zone of beta-hemolysis.
Laked Blood Kanamycin and Vancomycin Agar (LKV)
This agar is helpful for the isolation and partial identification of obligate anaerobic gram-negative bacilli, especially Prevotella species. It is an enriched, differential, and selective medium.
The medium comprises casein, meat peptone, soy peptone, dextrose, and yeast extract for the nutritional compounds required to grow gram-negative bacilli.
Kanamycin and Vancomycin are selective agents that prevent the growth of most obligate gram-positive and facultative anaerobic bacteria. Laked sheep blood and vitamin K1 facilitate the recovery and pigment production of Prevotella melaninogenicaand Porphyromonasspecies.
References
- Madigan Michael T, Bender, Kelly S, Buckley, Daniel H, Sattley, W. Matthew, & Stahl, David A. (2018). Brock Biology of Microorganisms (15th Edition). Pearson.
- Color Atlas and Textbook of Diagnostic Microbiology, Koneman, 5th edition
- Bailey & Scott’s Diagnostic Microbiology, Forbes, 11th edition
- Facklam and Washington. (1991). In Balows, Hausler, Hermann, Isenberg and Shadomy (ed.), Manual of clinical microbiology, 5th ed. American society of microbiology, Washington, D.C.